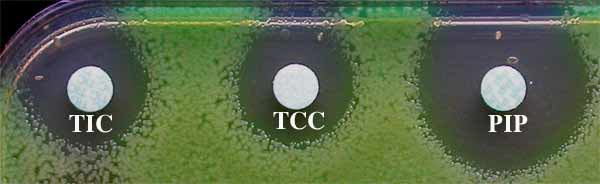

A - INTRODUCTION
La résistance, en particulier acquise aux antibiotiques, bien qu'observée dès la découverte de la pénicilline G avec le staphylocoque doré est devenue un sujet de préoccupation entrainant depuis trop peu de temps, une réelle prise de conscience au plan national ou international. La mise en place de réseaux de surveillance comme en France l'ONERBA (http://www.onerba.org/) ou encore le réseau européen EARSS (http://www.earss.rivm.nl/) atteste de cette préoccupation d'autant que la mise sur le marché (AMM) de nouveaux antibiotiques est devenue parcimonieuse depuis plusieurs années.


D'un point de vue clinique, seule est réellement essentielle, la résistance clinique qui signifie échec du traitement. Si le terme de souche "résistante" a déjà été évoqué dans les définitions de catégorie clinique et classe thérapeutique d'autres types de résistance peuvent évoqués comme ci-dessous : naturelle (spectre étroit des antibiotiques), acquise (mutation), chromosomique, plasmidique, croisée, associée.............
| Objectifs d'aujourd'hui Quelles sont les principales caractéristiques de la résistance bactérienne ? Quelles définitions de la résistance bactérienne pourriez-vous donner ? Quels sont les principaux mécanismes biochimiques que vous connaissez ? Quels sont les principaux mécanismes génétiques connus ? Pouvez-vous en donner des exemples ? |
B - PRINCIPALES CARACTÉRISTIQUES DE LA RÉSISTANCE BACTÉRIENNE :
La résistance bactérienne aux antibiotiques a souvent été rapportée dès l'usage d'un nouvel antibiotique en clinique comme indiqué ci-dessous pour les ß-lactamines, principale famille. La résistance bactérienne est donc une fatalité mais d'importance variable selon le pays, l'espèce bactérienne et l'antibiotique, victime de son succès.
La résistance bactérienne dite acquise présente certaines caractéristiques ci-dessous évoquées:
- Emergence rapide de quelques souches résistantes après l'introduction d'un antibiotique

- Fréquence de ce nouveau mécanisme rapidement en augmentation mais variable selon l'antibiotique. L'émergence de la résistance des pneumocoques à la pénicilline G constitue une exception, puisqu'elle est apparue en France en 1984, alors que la pénicilline G a été utilisée dès les années 45. Ce décalage, peu habituel, est en relation avec un déterminisme génétique plus complexe qu'à l'accoutumée (cf déterminisme génétique).

- Résistance transférable, car liée à la présence de gènes transférables comme ceux intégrés dans un plasmide, un intégron ou plus récemment avec l'individualisation de gènes cassettes (cf génétique IV).
- Ces génes transférables peuvent avoir une diffusion épidémique au sein du monde bactérien comme celui-ci codant la ß-lactamase TEM identifiée dans des souches de E. coli et de P. mirabilis, deux ans après l'introduction de la première pénicilline à large spectre, l'ampicilline.

- Enfin diverses observations illustrent le potentiel évolutif d'un gène de résistance bactérien avec, comme exemple, la découverte dans les années 85, des ß-lactamases à spectre élargi ou étendu (BLSE) et, quelques années après, celles TRI/IRT, résultats de mutations dans des positions différentes du gène codant pour l'enzyme précédemment citée TEM-1 ou TEM-2

La résistance acquise peut être donc, modulable permettant au monde bactérien, une adaptation possible aux thérapeutiques, mêmes les plus récentes.
C - DEFINITIONS DE LA RESISTANCE
* naturelle : Existence d'un ou plusieurs mécanismes de résistance innés, donc propres à l'espèce. Elle permet de définir le spectre clinique d'un antibiotique.
Exemple: résistance en cocarde à la colistine de Serratia marcescens

* acquise : acquisition d'un mécanisme de résistance pour une souche d'une espèce habituellement sensible
Exemple: résistance acquise aux pénicillines (amoxicilline ou AMX) et ticarcilline ou TIC) chez E. coli (à droite souche sauvage)


* clinique : expression de la résistance in vivo par l'échec thérapeutique
Exemple: résistance clinique à la pipéracilline (PIP) lors de pneumopathie à Klebsiella pneumoniae de phénotype "pénicillinase de bas niveau", résistante à l'amoxicilline (AMX) et à la ticarcilline (TIC)

* croisée : fait référence au spectre d'inactivation lié à un même mécanisme de résistance vis-à-vis de divers antibiotiques appartenant à la même famille ou sous-groupe. Cette notion est utilisée lors de lecture interprétative de l'antibiograme.
Exemple: consulter le communiqué du CA-SFM
(http://www.sfm.asso.fr/nouv/general.php?pa=2)

* chromosomique : résistance liée au chromosome. Il s'agit aussi d'expliquer le déterminisme génétique d'une résistance naturelle ou acquise dont le ou les gènes est ou sont liés au chromosome (mutation)
* génétique : modification du patrimoine génétique entraînant des augmentations limitées de CMI (X 3-5), souvent peu apparente
De légères modifications du patrimoine génétique d'une bactérie peuvent entraîner une moindre sensibilité à un antibiotique ou plusieurs de la même famille ou de plusieurs selon le mécanisme. Celles-ci sont révélées lors de la détermination de CMI ou par une diminution des diamètres d'inhibition dans un antibiogramme par diffusion (méthode des disques)(cf antibiotique IV). L'échec clinique n'est pas rapporté pour de telles souches de sensibilité diminuée.

Exemple: E. coli et imperméabilité par rapport aux quinolones (NA, acide nalidixique)

* extrachromosomique : La résistance est liée à la présence d'un fragment d'ADN, le plus souvent en position cytoplasmique tel un ADN plasmidique révêlé après une électrophorère sur gel (cf plasmide ci-dessous):
* associée : résistance médiée par un plasmide à des antibiotiques de familles différentes (cf résistance plasmidique transposable)(cf génétique IV)
Exemple : Chez P. aeruginosa, le plasmide (montré ci-dessous) est responsable de plusieurs marqueurs de résistance aux antibiotiques mais aussi aux antiseptiques (mercure) ou encore au tellurite.


* plasmidique: support génétique de la résistance (cf extrachromosomique ci-dessus et cours Génétique III).
Exemple: Contenu plasmidique d 'une souche de P. aeruginosa (à gauche) et de E. coli réceptrice avant (à droite) et après transfert (au milieu) par conjugaison. Le plasmide de plus de 150 kD confère la résistance à plusieurs familles d'antibiotiques ou encore aux antiseptiques..........


* transposable : localisée sur des transposons (Tn) ou éléments génétiques mobiles, situés soit dans le chromosome, soit sur un plasmide.
Exemple: Mobilisation d'un transposon (Tn) d'une bactérie donatrice à gauche à une réceptrice par conjugaison (schéma selon Poyart C.) .

D - MECHANISMES BIOCHIMIQUES :
Préciser le déterminisme biochimique de la résistance amène à comprendre la résistance croisée entre antibiotiques de la même famille ou encore à imaginer de nouvelles molécules plus actives, car plus hydrophiles, donc ayant une meilleure diffusion à travers les porines chez une bactérie à Gram-négatif ou une meilleure affinité sur ses cibles telles certaines protéines du ribosome (macrolides).
A l'inverse, le mode d'action des antibiotiques peut permettre une meilleure compréhension des mécanismes de résistance possibles. Depuis quelques années, cinq mécanismes peuvent être envisagés pour expliquer la résistance naturelle ou surtout acquise des bactéries aux antibiotiques.
| Prenons l'exemple des ß-lactamines chez un bacille à Gram-négatif, qui pour agir, doivent traverser la membrane externe ou la paroi au niveau des porines (motif en bleu), puis traverser l'espace cytoplasmique et enfin se fixer sur des cibles ou protéines liant la pénicilline (PLP ou PBPs en marron) qui sont situées principalement au niveau de la membrane cytoplasmique. Cette fixation amène à une inhibition de celles-ci (transpeptidase, transglycosylase....) entraînant des modifications morphologiques de type filaments (cf ci-dessous) ou au contraire formes sphéroïdes. Le résultat final est une inhibition de la synthèse du peptidoglycane (couche interne de la paroi en rose ici) avec quelquefois, une lyse finale. |
 |
Exemple: modification morphologique (à droite) d'une souche de E. coli urinaire lors d'un traitement par une pénicillline à large spectre.


Les mécanismes de résistance individualisés à l'heure actuelle, en prenant comme exemple les ß-lactamines, sont donc, les suivants:
* Interférence avec le mécanisme de transport de type imperméabilité
| Les porines (Omp ou Opr) sont des canaux aqueux ou hydrophiles constitués de trois molécules de protéines qui laissent diffuser diverses molécules de faible masse moléculaire comme des substrats ou encore des antibiotiques. Le dysfonctionnement ou la perte de l'une d'entre elles peut entrainer une augmentation de CMI d'un facteur 4 à 8 de divers antibiotiques comme ß-lactamines, acide nalidixique (NA), triméthoprime (TMP), fosfomycine, tétracycline (TE) ou encore chloramphénicol (C) (Exemple ci-dessous).
Chez d'autres entérobactéries telle Enterobacter cloacae ou E. aerogenes, la perte d'une porine (38 kD) associée à une hyperproduction de la ß-lactamase chromosomique de type céphalosporinase permet l'acquisition de la résistance aux carbapénèmes tel imipénème. |
 |
Exemple d'une souche de E. coli imperméable

* Interférence avec le mécanisme de transport de type efflux
| Les mécanismes d'efflux observés chez les bactéries à Gram-positif ou à Gram-négatif, en particulier P. aeruginosa sont de nature différente ( famille MFS, SNR, RDN....), en particulier à l'origine chez cette dernière espèce où ont été individualisés les systèmes ayant des répercutions variables en termes de CMI vis-à-vis de divers antibiotiques dont les ß-lactamines avec les protéines MexA-B/OprM, MexC-D/OprJ, MexE-F/OprN..................
Voulez-vous voir une animation: http://www.fda.gov/cvm/antiresistvideo.htm |
 |
Exemple d'activation du système d'efflux MexA-B/OprM chez P.aeruginosa avec la sensibilité diminuée à la ticarcilline (TIC) associée ou non à l'acide clavulanique (TCC) comparée à celle de la pipéracilline (PIP)
* Inactivation ou détoxification enzymatique
| Le mécanisme de résistance naturelle ou acquise par inactivation ou détoxification enzymatique est important et très varié ainsi qu'en témoignent tout particulièrement, les ß-lactamases, au moins 350 enzymes maintenant identifiées. La résistance par ce type de mécanisme à d'autres familles d'antibiotiques est bien connue comme pour les aminoglycosides avec les enzymes de AAC, ANT et APH (cf tableau ci-dessous).
Voulez-vous voir une animation: http://www.fda.gov/cvm/antiresistvideo.htm |
 |


Le caractère "inductible" est répérable par un antagonisme ou perte d'activité liée à l'hyperproduction de la ß-lactamase entre CF (céfalotine) et FOX (céfoxitine) mais surtout entre IPM (imipénème) et CTX (céfotaxime) ou ATM (aztréonam).
* Modification d'affinité de la cible
| Ce mécanisme est en relation avec une modification d'affinité d'une ou plusieurs cibles de type PLP ou PBP (Penicillin Binding Protein) comme chez Streptococcus pneumoniae définissant une résistance de niveau variable : BNR (bas niveau de résistance) et HNR (haut niveau de résistance). La résistance des entérocoques aux pénicillines telle l'ampicilline peut être en relation avec une hyperproduction de PLP d'affinité médiocre telle PLP5. La résistance à d'autres familles d'antibiotiques est indiquée dans un tableau de synthèse rapporté ci-dessous. |
 |
Exemple de diminution de CMI de la pénicilline G (PG) et du céfotaxime (TX) mesurées par le E-test chez une souche de S. pneumoniae BNR

* Substitution de cible
| Ce mécanisme est de moindre importance dans le monde bactérien. Cependant, l'exemple majeur est la résistance intrinsèque ou méticillino-résistance de Staphylococcus aureus qui est liée d'une part, à la présence d'une nouvelle PLP de faible affinité, dénommée PLP2a et d'autre part à son hyperproduction. La conséquence clinique est importante, car il y aura résistance croisée entre ß-lactamines. |
 |
Le tableau ci-dessous résume divers exemples de résistance naturelle ou acquise à diverses familles d'antibiotiques :
|
Mécanismes
|
Famille d'antibiotique
|
Protéines impliquées
|
| Imperméabilité | B-lactamines, macrolides, tétracy-clines, quinolones, fosfomycine, chloramphénicol......... |
Omp, Opr telle OprD2 |
| Efflux | ß-Lactamines Macrolides Lincosamides Tétracyclines |
Mex, Mar, AcrAB-TolC MFS (MefA), MsrA, ABC LsA TET(A)-(L) |
| Inactivation | ß-Lactamines Aminoglycosides Aminoglycosides Aminoglycosides Macrolides Lincosamides Streptogramines Chloramphénicol |
ß-Lactamases (> 350) Phosphotransférases (APH) Nucléotidyltransférases (ANT) Acétyltransférases (AAC) Phosphotransférases (mphA-C) Nucléotidyltransférases (linA, lnuA, linB....) Acétyltransférases (vatA-E), lyases (vgbA) Acétyltransférases (CAT) |
| Affinité | Aminoglycosides Macrolides Quinolones-Fluoroquinolones Tétracyclines |
Protéines L22........... Méthylases (Erm) Topoisomérases: ADNgyraseA/B, ParC/E TET(M)-(T) |
| Substitution | ß-Lactamines
Glycopeptides Sulfamides Triméthoprime |
PLP2a Van DHFR (dihydrofolate réductase) DHPS (dihydroptéroate synthétase) |
E - MECANISMES GENETIQUES (cf Génétique I et III) :
Le déterminisme génétique de la résistance naturelle et acquise est de mieux en mieux connu mais il présente de nombreux aspects comme déjà évoqué par les définitions de la résistance : chromosomique, extra-chromosomique ou plasmidique mais aussi transposable..... Pour plus de détails, consulter les cours de Génétique I, II, III, IV et V.
- Si la mutation (cours de Génétique I) peut affecter n'importe quel ADN (chromosomique ou plasmidique), elle peut être individualisée soit au niveau du gène de régulation ou un équivalent (promoteur) soit au niveau du gène de structure par exemple codant pour une ß-lactamase (voir ci-dessous les enzymes de type BLSE et TRI/IRT).La modification de l'ADN peut être soit un simple changement de base (mutation ponctuelle) soit de plusieurs (déletion, insertion comme d'une courte séquence ou IS).
Voulez-vous voir une animation: http://www.fda.gov/cvm/antiresistvideo.htm
- L'acquisition d'ADN donc d'éventuels gènes de résistance s'effectue, le plus souvent par conjugaison ou sexualité bactérienne (cours de Génétique II). Ces gènes sont portés sur diverses structures de type plasmide, intégron et gène cassette (cours de Génétique III et IV). Les analyses de séquences actuelles conduisent à la découverte de nouveaux aspects génétiques sur la résistance avec les CR et leurs probables recombinases.
Le tableau ci-dessous illustre par quelques exemples :

- Il est classique de dire que la résistance chromosomique est d'incidence faible, de l'ordre de 10 à 20% alors que la résistance plasmidique est beaucoup plus importante, de l'ordre de incidence de 80%
F - CONCLUSIONS
A partir des années 1945, les antibiotiques ont révolutionné nos pratiques médicales, mais ils sont aujourd'hui en danger suite à une utilisation excessive et trop fréquente, même en dehors du domaine purement médical. Les bactéries échangent divers gènes dont ceux de la résistance et échappent à l'action des antibiotiques. Comme la découverte de nouveaux antibiotiques est devenue très hypothétique, il convient de mettre en oeuvre au plan planétaire, diverses stratégies comme la surveillance de la résistance avec en France, l'ONERBA et au plan européen, l'EARSS.
Il conviendra de resteindre l'usage des antibiotiques à leur strict nécessaire. Des campagnes de sensibilisation auprès des patients seront entreprises comme maintenant en France ou dans d'autres pays.
 |
 |
| Parmi les autres mesures, il conviendra au niveau de l'hôpital, de surveiller l'émergence de souches multirésistances (BMR)(création des CLIN, comité de lutte contre l'infection nosocomiale), mesures d'isolement des malades......... |
 |
Il conviendra aussi de respecter rigoureusement les règles d'hygiène comme l'application de protocoles concernant la pose de cathéter ou la désinfection des endoscopes............
 |
 |
 |
 |
Resteindre leur usage comme activateurs de la croissance dans l'alimentation animale.

Pour en savoir plus :
http://anne.decoster.free.fr/atb/resab.htm
http://www.antibiotiques-info.org/ures09.asp
http://lyon-sud.univ-lyon1.fr/bacterio/college/HC99/Resistab/index.html
http://www.who.int/csr/
http://www.frm.org/informez/
http://www.doctissimo.fr/html/sante/mag_2000/mag0721/sa_1879_france-resistances.htm
http://www.ccar-ccra.com/french/home-f.shtml
http://www.invs.sante.fr/beh/2004/32_33/
Ce cours a été préparé par le Professeur A. PHILIPPON (Faculté de Médecine René Descartes, Université PARIS V)(V2-30.12.04)
Pour en savoir plus:

|
|
|
|
|
